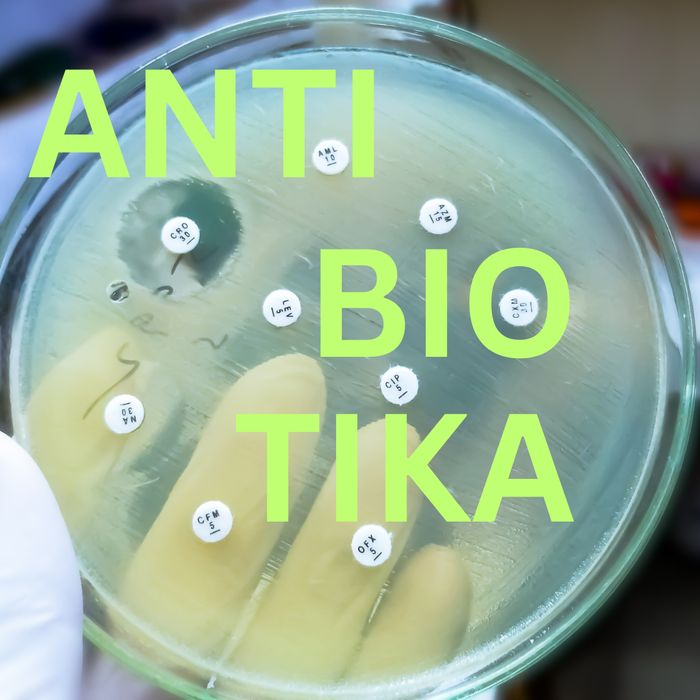
img antibiotika

GPM-Networking Days am 22. und 23. März 2024 in Hannover
Am 22. und 23. März 2024 finden die ersten GPM-Networking Days in Hannover statt. Im Rahmen der Vortragsveranstaltung am Freitag, dem 22. März 2024 liegt im Herrenhäuser Schloss der Fokus auf der Sportmedizin. Daneben sind Impulsvorträge und eine Diskussionsrunde zum Einfluss künstlicher Intelligenz (KI) in der Tiermedizin vorgesehen. Im Anschluss an den Kongress ist die GPM-Mitgliederversammlung vorgesehen, bevor der Abend mit einer Afterwork-Party ausklingt. Am Samstag, dem 23. März 2024 erwarten die Teilnehmenden in der Pferdeklinik der TiHo Hannover u.a. Workshops mit international renommierten ReferentInnen zur Kaufuntersuchung, orthopädischen Ultrasonographie, Echokardiographie, Rationsberechnung, Röntgenaktualisierung und Anwendung der GOT. Das ausführliche Programm finden Sie HIER.
Sichern Sie sich HIER Ihre Tickets in unserem Shop!
GPM – Networking Days am 22./23. März 2024
Hannover Schloss Herrenhausen und Klinik für Pferde, TiHo Hannover
Vortragsprogramm am Freitag, 22.03.2024
Auditorium Schloss Herrenhausen
Orthopädie
08:15 Uhr Begrüßung
08:30 Uhr Equine neurectomy: techniques and indications
Dr. B. Bladon, DipECVS, Donnington Grove Veterinary Group, UK
09:00 Uhr Is it always the neck?
Prof. J.-M. Denoix, DipECVSMR, CIRALE-NEV-ENVA, France
09:30 Uhr Equine Complex Vertebral Malformation (ECVM) beim Sportpferd
Dr. M. Hellige, DipECVDI, Tierärztliche Hochschule Hannover
10:00 Uhr Standing orthopaedic surgery in sport horses - options, indications and limitations
Dr. B. Bladon, DipECVS, Donnington Grove Veterinary Group, UK
10:30 -11:00 Uhr Networking – Kaffeepause
11:00 Uhr Trainingskonzepte und Gesunderhaltung des Athleten "Mensch"
Prof. Dr. U. Tegtbur, Medizinische Hochschule Hannover
11:30 Uhr Carpal flexor retinaculum desmopathies in sport horses
Prof. J.-M. Denoix, DipECVSMR, CIRALE-NEV-ENVA, France
12:00 Uhr Früherkennung von Lahmheiten: Was kann Ganganalyse leisten?
Prof. Dr. F. Geburek, DipECVSMR, Tierärztliche Hochschule Hannover
12:30 -14:00 Uhr Networking - Mittagpause
Künstliche Intelligenz in der Medizin
14:00 Uhr Impulsvortrag I: Was ist KI und wie unterscheidet sie sich von herkömmlichen Algorithmen?
Prof. Dr. T. M. Deserno, Peter L. Reichertz Institut für Medizinische Informatik
der TU Braunschweig und der Medizinischen Hochschule Hannover
14:30 Uhr Impulsvotrag II: Bildanalyse mit KI - wie wird sie angelernt und was leistet sie
bereits in der Humanmedizin?
Prof. Dr.-Ing. Steffen Oeltze-Jafra, Peter L. Reichertz Institut für Medizinische
Informatik der TU Braunschweig und der Medizinischen Hochschule Hannover
14:30 Uhr Podiumsdiskussion mit Gästen und Teilnehmern
15:30 -16:30 Uhr Networking - Kaffeepause
Innere Medizin und Zahnmedizin
16:30 Uhr Welche Rolle spielt das Herz?
Prof. Dr. C. Hopster-Iversen, DipECEIM, University of Copenhagen, Department
of Veterinary Clinical Sciences
17:00 Uhr "Performance Floating" - was ist an Pferdezähnen möglich?
Dr. C. Vogt, Tierarztpraxis Ottersberg
17:30 Uhr Dysfunktion der oberen Atemwege. Welche Optionen bietet die Chirurgie?
Dr. Olivier Brandenberger, DECVS, Hanseklinik für Pferde, Sittensen
18:00 Uhr GPM-Mitgliederversammlung
19:30 Uhr Networking – Party
Workshops am Samstag, 23.03.2024
Klinik für Pferde, Stiftung Tierärztliche Hochschule Hannover
09:00 - 11:00 Uhr und 11:30 - 13:30 Uhr
Workshop 1: Röntgenaktualisierung
Dr. M. Hellige, DipECVDI, Tierärztliche Hochschule Hannover
Workshop 2: Anwendung der GOT
Dr. D. Meister, Medizinisches Pferdezentrum Stephansmühle
Workshop 3: Kaufuntersuchung
Dr. M. Köhler, Fachtierärztliche Praxis für Pferde in Wusterhausen
Workshop 4: Sonographie Gliedmaßen
Prof. J.-M. Denoix, DipECVSMR, CIRALE-NEV-ENVA, France
Workshop 5: Sonographie Hals – Rücken – Becken
Prof. J.-M. Denoix, DipECVSMR, CIRALE-NEV-ENVA, France
Workshop 6: Pferdefütterung: Rationsberechnung
Prof. I. Vervuert, Universität Leipzig
Dr. Martin Gundel, Tierärztliche Praxis für Pferde in Ratingen
Workshop 7: Kardiologie I + II
Prof. Dr. C. Hopster-Iversen, DipECEIM, University of Copenhagen, Department
of Veterinary Clinical Sciences
Lesen »
Das Gesetzes zur Änderung des TAMG und ApoG wurde heute im Bundesrat verabschiedet, so dass es am 01.01.2026 in Kraft treten kann. Wichtig für die Kollegen der Kleintiermedizin: der Start zur Meldung der Jahresverbrauchsmengen an Antibiotika verschiebt sich auf Januar 2030 (für 2029).
Das Gesetzes zur Änderung des TAMG und ApoG wurde heute im Bundesrat verabschiedet, so dass es am 01.01.2026 in Kraft treten kann. Wichtig für die Kollegen der Kleintiermedizin: der Start zur Meldung der Jahresverbrauchsmengen an Antibiotika verschiebt sich auf Januar 2030 (für 2029).






